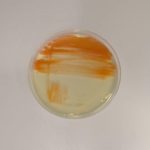

Mamy kolejny powód do dumy – firma BACTrem zdobyła III miejsce w kategorii Innowacyjna Firma w XVII edycji konkursu Innowator Mazowsza. Nagrodę otrzymaliśmy za opracowanie niskoemisyjnej technologii utylizacji niebezpiecznych odpadów drewnianych impregnowanych olejem kreozotowym – unikalnego na skalę Europy, kompleksowego rozwiązania w duchu zero waste, które pozwoli wyeliminować te rakotwórcze materiały.
Innowator Mazowsza – wyróżnienia dla najlepszych
Do tegorocznej, XVII edycji konkursu „Innowator Mazowsza”, organizowanego przez samorząd województwa mazowieckiego, zgłosiło się 30 firm z naszego regionu. Projekty były oceniane przez grono 34 ekspertów – pod kątem innowacyjności, wpływu na otoczenie oraz potencjału wdrożeniowego. Łączna pula nagród wyniosła 118 tysięcy złotych.
Gala finałowa konkursu odbyła się 6 listopada 2025 roku. BACTrem zajęło III miejsce, a nasz projekt cieszył się wyjątkowym zainteresowaniem oraz uznaniem.

Rozwiązanie BACTrem – rewolucja w utylizacji niebezpiecznych odpadów drewnianych impregnowanych olejem kreozotowym
Kreozot to substancja stosowana do konserwacji drewna od 1839 roku. Składa się ze skomplikowanej mieszaniny setek różnych związków chemicznych, w tym wielopierścieniowych węglowodorów aromatycznych, np. rakotwórczego benzo(a)pirenu.
Nie dziwi więc, że od 1 maja 2013 roku Unia Europejska uznaje kreozot za bezprogowy czynnik rakotwórczy kategorii 1B – co oznacza, że stanowi poważne zagrożenie dla zdrowia i życia ludzi oraz środowiska naturalnego.
W Polsce skala problemu jest ogromna, w szczególności na kolei. Konieczna jest modernizacja około 9 tys. km torowisk kolejowych, a co za tym idzie utylizacja ponad 15 mln drewnianych podkładów kolejowych. To prawie 975 mln ton niebezpiecznych odpadów.
Do niedawna nie istniała bezpieczna, skuteczna metoda ich przetwarzania, a media coraz głośniej biły na alarm – wskazując na potężne zagrożenieśrodowiskowe i zdrowotne.
Technologia fizyczno-chemiczno-biologiczna – odpowiedź BACTrem na kreozot
Zespół BACTrem podjął wyzwanie i już w 2019 roku, po przeprowadzeniu szeroko zakrojonych badań rozpoczął proces wdrożenia innowacyjnej technologii fizyczno-chemiczno-biologicznej.
Nasycalnia Podkładów w Pludrach, której od 2022 roku udzielamy licencji na wykorzystanie tej technologii, dysponuje obecnie pozwoleniem na przetwarzanie46 tys. t rocznie odpadu o kodzie 17 02 04*, przy czym techniczne możliwości zakładu sięgają nawet 120 tys. t rocznie.
To jedyna obecnie dostępna w Polsce bezpieczna technologia przetwarzania tego typu odpadów o potwierdzonej skuteczności, prowadząca do odzysku surowca. Proces polega – zgodnie z nazwą – na złożonej obróbce fizycznej, chemicznej i biologicznej zanieczyszczonego drewna. W efekcie otrzymujemy odpad bezpieczny (kod 19 12 10), który może być wykorzystany jako surowiec energetyczny.
Co daje wdrożenie rozwiązania BACTrem?
Innowacyjna technologia, którą opracowaliśmy, przynosi wymierne korzyści dla środowiska, zdrowia, a także ekonomiczne.
Jej wdrożenie prowadzi do rzeczywistej eliminacji niebezpiecznego odpadu z rynku. Zmniejsza szkodliwe oddziaływanie na ludzi, zwierzęta i środowisko naturalne, przyczyniając się do poprawy bezpieczeństwa, zdrowia publicznego i ochrony bioróżnorodności – aspektów istotnych dla jakości życia.
Nasze rozwiązanie wpisuje się też w zasady zrównoważonego rozwoju: ogranicza emisję zanieczyszczeń, chroni bioróżnorodność i pozwala racjonalnie gospodarować zasobami. To praktyczny dowód na to, jak nowoczesna biotechnologia może odpowiadać na potrzeby środowiska i społeczeństwa.
Za sukcesem BACTrem stoi zespół ekspertów, którzy łączą kompetencje z zakresu mikrobiologii, biotechnologii, chemii, technologii drewna oraz procesów oczyszczania. Są to:
- mgr Andrzej Berezowski – odpowiedzialny za zarządzanie na poziomie operacyjnym;
- mgr Rafał Ostrowski – mikrobiolog, biotechnolog, Kierownik działu ds. badań i rozwoju produktów;
- dr inż. Magdalena Zalewska – chemik, biotechnolog (Wydział Biologii UW);
- dr hab. Magdalena Popowska, prof. UW – Prezes Zarządu BACTrem, ekspert w zakresie biodegradacji związków toksycznych oraz tworzenia biopreparatów bakteryjnych opartych na synergistycznym działaniu, mikrobiolog, biotechnolog;
- dr hab. Andrzej Radomski – ekspert w zakresie technologii drewna i procesów chemicznych, chemik (Instytut Nauk Drzewnych i Meblarstwa SGGW w Warszawie)
- dr hab. inż. Rafał Bray, prof. ucz. – ekspert w dziedzinie procesów oczyszczania wód z zastosowaniem procesów fizyczno-chemicznych i biologicznych, chemik (Katedra Technologii Wody i Ścieków Wydziału Inżynierii Lądowej i Środowiska Politechniki Gdańskiej).
Dziękujemy organizatorom konkursu, ekspertom oceniającym projekty oraz wszystkim, którzy wspierają nasze działania. Wierzymy, że już wkrótce, dzięki naszemu rozwiązaniu, problem utylizacji niebezpiecznych odpadów drewnianych impregnowanych olejem kreozotowym zostanie całkowicie wyeliminowany, z korzyścią dla ludzi i środowiska.